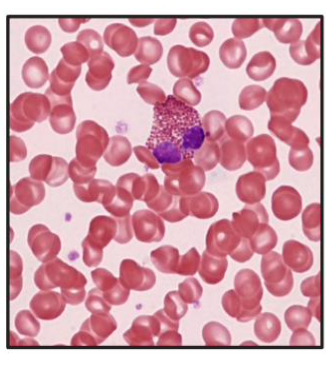
<p></p>
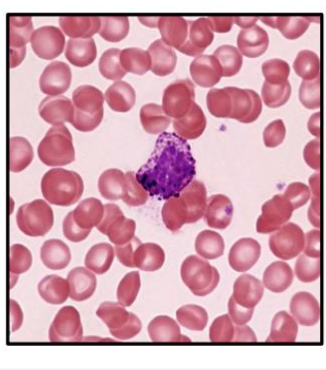
<p></p>
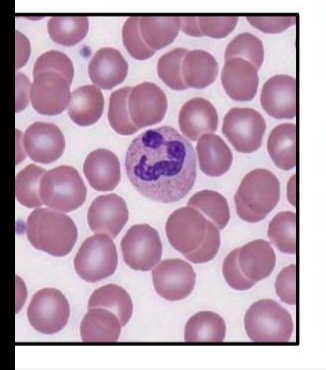
<p></p>
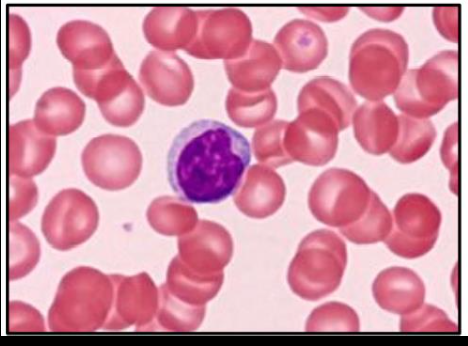
term image
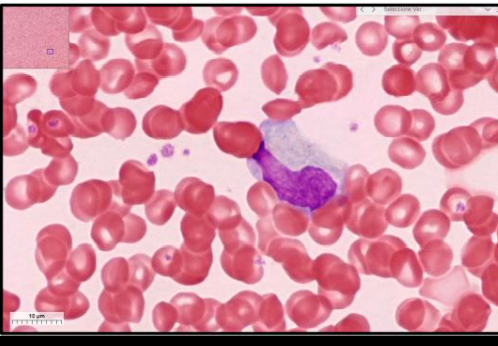
term image
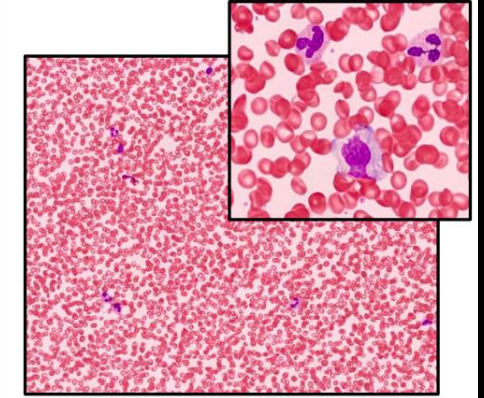
term image

1/19
Looks like no tags are added yet.
Name | Mastery | Learn | Test | Matching | Spaced | Call with Kai |
|---|
No analytics yet
Send a link to your students to track their progress
LEUCITO GRANULOCITOS - EOSINOFILOS
LEUCITO GRANULOCITOS - BASOFILOS
LEUCITO GRANULOCITOS - NEUTROFILOS

NEUTROFILOS

EOSINOFILOS

BASOFILO
Leucocitos Agranulocitos - Linfocitos
Leucocitos Agranulocitos - MONOCITOS

MONOCITOS

LINFOCITOS

Blastos (C茅lulas Madres)

Eritrocitos Nucleados (Normoblastos)

Megacariocito

Mielocito Neutr贸filo

Neutr贸filo En Banda

Metamielocito Neutr贸filo

Frotis de M茅dula 脫sea
Frotis de Sangre Perif茅rica

EOSIN脫FILOS

NEUTR脫FILOS